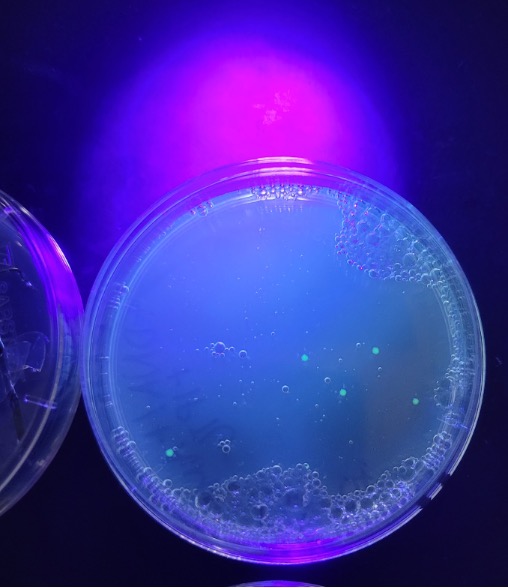

EDVO-Kit #223-AP08 Transformation of E. coli with Green Fluorescent Protein (GFP)
This is a guest post from Sarah Hawley, a biomedical science teacher at Richmond High School, IN.
Last year I was a 21st year teacher in my first year of teaching a 4th year Biomedical Science class. Suffice to say, I felt like a novice teacher all over again when it comes to the content that I taught. But oh, how I enjoyed it! I was lucky enough to have been chosen to be a social media affiliate for Edvotek. In exchange for my honest review of one of their kits, I received said kit free to try with my students. I jumped at the chance to include a lab very similar to one they had missed in a previous year due to Covid. And that is how my students and I got to be the lucky recipients of Edvotek kit 223-AP08 Transformation of E.coli with Green Fluorescent Protein.
The kit arrived quickly, the day after I was notified that it had been shipped. I was excited to delve into the teacher materials and learn what I needed to know in order to guide my students to what they needed to know in order to get the most out of this lab. I’ve never before taught a thing about gene editing. In fact, I’ll let you in on a not-so secret secret…I only ever took one course in college about how to teach science. I started out as an elementary education teacher and worked my way up to teaching high school science, taking the appropriate training and tests to add to my license as I went. Needless to say, much of what I have been teaching my students this year, I had to teach myself first. This also means that the instructions provided with this kit left me feeling comfortable enough to safely guide 33 teenagers through handling live E.coli bacteria, and genetically altering it to be antibacteria resistant.
Preparing to teach this was minorly stressful. I wanted to be sure I explained things well enough that my students understood, but without dumbing things down too much. This meant reading the instructions, watching online videos so that I could understand the scientific background, and mulling over how I wanted to handle materials distribution. At first, I wanted my students to have more to do with the lab prep, particularly pouring the agar plates. Unfortunately, I just couldn’t make this happen for two separate classes of students. I would love to see the preparation of the plates become part of the experience of this lab. Not only would the students gain some experience with a new skill, but they would also have more of an understanding about what was on each plate because they would have added the reagents and chemicals for each step themselves. I would still love to see this lab altered a bit to include students pouring the plates as a piece of the lab. This would require different packaging for the agar, growth additive, ampicillin, and IPTG. I am not sure of the feasibility of this idea considering the small volume of ampicillin and the cost of the added packaging. I ended up preparing all the plates myself. It didn’t take long, but I discovered that the pipette bulb we had in the lab had dry rotted. So I measured the agar into my first plate using a 1,000 uL pipette and then made the others look about like the first plate. I was worried I would run out of agar and may have been too conservative in my estimates for the rest of the plates. I ended up with a little extra agar at the end, so I may not have used enough in some of the plates. The agar in some of the smaller plates cracked in the incubator. I believe it was because these plates did not have enough agar. It also could have been too dry, as it was still quite cold and dry out when we completed the lab. Things I will do differently the next time around are investing in a 10mL pipette controller so that my measurements are more accurate and placing a beaker of distilled water in the corner of the incubator to keep the humidity up.
My students had never streaked plates before this lab, so we spent a day or two learning about how and why scientists streak plates. My students did rather well streaking the plates this time, with only one group cutting slightly into the agar on one plate. I count this as success for first-time bacteriologists.
All went well for most of the lab, but we discovered that the pool noodle foam blocks we had on hand to float the microcentrifuge tubes in the water bath did not allow the tubes to submerge into the water enough. This was soon remedied by cutting the blocks in half which then allowed the tubes to touch the water in the hot water bath.
I used the original protocol for bacterial source plate preparation this time around. I think when I teach this lab again, I would like to prepare my bacteria using the enhanced transformation protocol. It would be interesting to compare my students’ results next time to the results we got this time.
When all was complete, we had one out of ten groups successfully transform their bacteria. Though this is a low number, we used it as a teachable moment to reflect on possible reasons why only one group had successful transformation. Since we did have one success, students were all able to see what positive results looked like in this lab.
I would love to add more to what I teach as background knowledge of gene editing, especially when it comes to genetically modifying organisms to glow under a UV light so that you know the trait you are studying has been successfully modified. There is a lot of fascinating medical research developing around this technique. I’d be interested in seeing what my students can come up with for the possibilities this technology has to offer.